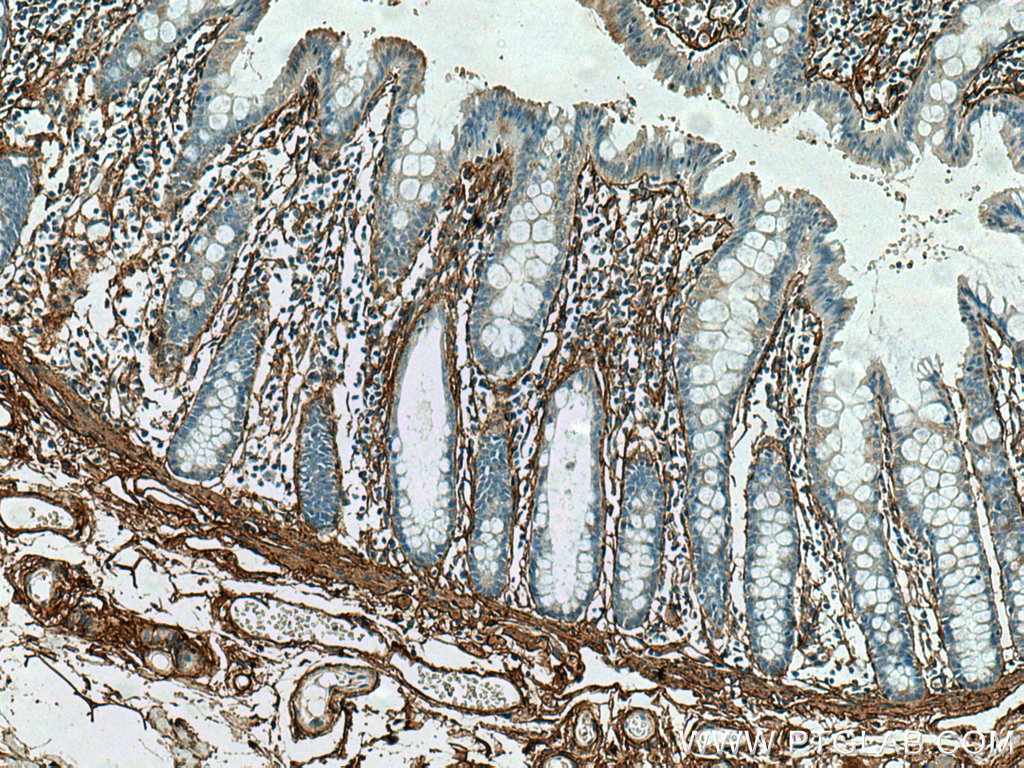

验证数据展示
经过测试的应用
| Positive WB detected in | mouse heart tissue, HEK-293T cells, human heart tissue, human skeletal muscle tissue, rat heart tissue |
| Positive IP detected in | mouse heart tissue |
| Positive IHC detected in | human colon tissue, human heart tissue, human hepatocirrhosis tissue, human kidney tissue, human liver tissue, human lung tissue, human placenta tissue, human skin cancer tissue, human spleen tissue, human testis tissue, mouse liver tissue Note: suggested antigen retrieval with TE buffer pH 9.0; (*) Alternatively, antigen retrieval may be performed with citrate buffer pH 6.0 |
| Positive IF-P detected in | human colon tissue, mouse skeletal muscle tissue |
| Positive IF detected in | mouse skeletal muscle tissue |
推荐稀释比
| 应用 | 推荐稀释比 |
|---|---|
| Western Blot (WB) | WB : 1:1000-1:4000 |
| Immunoprecipitation (IP) | IP : 0.5-4.0 ug for 1.0-3.0 mg of total protein lysate |
| Immunohistochemistry (IHC) | IHC : 1:300-1:1200 |
| Immunofluorescence (IF)-P | IF-P : 1:50-1:500 |
| Immunofluorescence (IF) | IF : 1:20-1:200 |
| It is recommended that this reagent should be titrated in each testing system to obtain optimal results. | |
| Sample-dependent, Check data in validation data gallery. | |
产品信息
17023-1-AP targets COL6A1 in WB, IHC, IF, IF-P, IP, ELISA applications and shows reactivity with human, mouse, rat samples.
| 经测试应用 | WB, IHC, IF, IF-P, IP, ELISA Application Description |
| 文献引用应用 | WB, IHC, IF |
| 经测试反应性 | human, mouse, rat |
| 文献引用反应性 | human, mouse, rat, pig, zebrafish, sheep |
| 免疫原 |
CatNo: Ag10288 Product name: Recombinant human COL6A1 protein Source: e coli.-derived, PGEX-4T Tag: GST Domain: 680-1028 aa of BC052575 Sequence: SIRNVQELKEAIKSLQWMAGGTFTGEALQYTRDQLLPPSPNNRIALVITDGRSDTQRDTTPLNVLCSPGIQVVSVGIKDVFDFIPGSDQLNVISCQGLAPSQGRPGLSLVKENYAELLEDAFLKNVTAQICIDKKCPDYTCPITFSSPADITILLDGSASVGSHNFDTTKRFAKRLAERFLTAGRTDPAHDVRVAVVQYSGTGQQRPERASLQFLQNYTALASAVDAMDFINDATDVNDALGYVTRFYREASSGAAKKRLLLFSDGNSQGATPAAIEKAVQEAQRAGIEIFVVVVGRQVNEPHIRVLVTGKTAEYDVAYGESHLFRVPSYQALLRGVFHQTVSRKVALG 种属同源性预测 |
| 宿主/亚型 | Rabbit / IgG |
| 抗体类别 | Polyclonal |
| 产品类型 | Antibody |
| 全称 | collagen, type VI, alpha 1 |
| 别名 | COL6, collagen 6A1, Collagen alpha 1(VI) chain, Collagen alpha-1(VI) chain, Collagen Type VI |
| 计算分子量 | 1028 aa, 109 kDa |
| 观测分子量 | 140 kDa |
| GenBank蛋白编号 | BC052575 |
| 基因名称 | COL6A1 |
| Gene ID (NCBI) | 1291 |
| RRID | AB_2229737 |
| 偶联类型 | Unconjugated |
| 形式 | Liquid |
| 纯化方式 | Antigen affinity purification |
| UNIPROT ID | P12109 |
| 储存缓冲液 | PBS with 0.02% sodium azide and 50% glycerol, pH 7.3. |
| 储存条件 | Store at -20°C. Stable for one year after shipment. Aliquoting is unnecessary for -20oC storage. |
背景介绍
Type VI Collagen is a major structural component of microfibrils. Type VI Collagen was found to be present throughout the connective tissue and in the extracellular matrix of cultured fibroblasts (PMID: 6723253). It is a heterotrimer composed of three different chains: alpha-1(VI), alpha-2(VI), and alpha-3(VI) or alpha-5(VI) or alpha-6(VI). The alpha-1(VI) chain is encoded by COL6A1 gene. Mutations in this gene result in Bethlem myopathy and Ullrich congenital muscular dystrophy.
实验方案
| Product Specific Protocols | |
|---|---|
| IF protocol for COL6A1 antibody 17023-1-AP | Download protocol |
| IHC protocol for COL6A1 antibody 17023-1-AP | Download protocol |
| IP protocol for COL6A1 antibody 17023-1-AP | Download protocol |
| WB protocol for COL6A1 antibody 17023-1-AP | Download protocol |
| Standard Protocols | |
|---|---|
| Click here to view our Standard Protocols |
发表文章
| Species | Application | Title |
|---|---|---|
Cell Death Differ Developmental growth plate cartilage formation suppressed by artificial light at night via inhibiting BMAL1-driven collagen hydroxylation | ||
Cancer Res Sarcoma Cells Secrete Hypoxia-Modified Collagen VI to Weaken the Lung Endothelial Barrier and Promote Metastasis | ||
Cell Rep The mechano-chemical circuit in fibroblasts and dendritic cells drives basal cell proliferation in psoriasis | ||
Matrix Biol Proteome-wide and matrisome-specific atlas of the human ovary computes fertility biomarker candidates and open the way for precision oncofertility. | ||
Oncogene Twist1-induced activation of human fibroblasts promotes matrix stiffness by upregulating palladin and collagen α1(VI). | ||
Cancer Gene Ther Schwann cell derived pleiotrophin stimulates fibroblast for proliferation and excessive collagen deposition in plexiform neurofibroma |